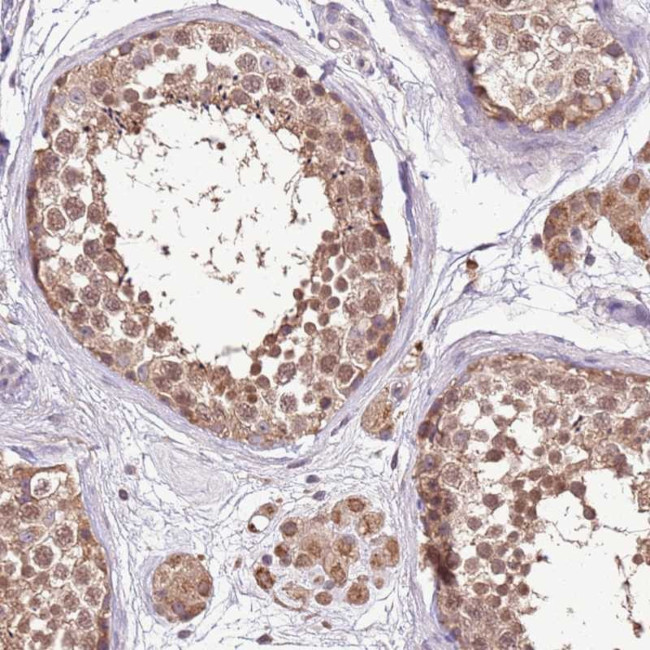
BBS5 Antibody in Immunohistochemistry (Paraffin) (IHC (P))

Search
Invitrogen
BBS5 Polyclonal Antibody
{{$productOrderCtrl.translations['antibody.pdp.commerceCard.promotion.promotions']}}
{{$productOrderCtrl.translations['antibody.pdp.commerceCard.promotion.viewpromo']}}
{{$productOrderCtrl.translations['antibody.pdp.commerceCard.promotion.promocode']}}: {{promo.promoCode}} {{promo.promoTitle}} {{promo.promoDescription}}. {{$productOrderCtrl.translations['antibody.pdp.commerceCard.promotion.learnmore']}}
产品信息
PA5-61158
种属反应
宿主/亚型
分类
类型
抗原
偶联物
形式
浓度
规格
纯化类型
保存液
内含物
保存条件
运输条件
RRID
产品详细信息
Immunogen sequence: DVRFDLSAQQ MKTRPGEVLI DCLDSIEDTK GNNGDRGRLL VTNLRILWHS LALSRVNVSV GYNCILNITT RTANSKLR
Highest antigen sequence identity to the following orthologs: Mouse - 92%, Rat - 92%.
靶标信息
The BBSome complex is thought to function as a coat complex required for sorting of specific membrane proteins to the primary cilia. The BBSome complex is required for ciliogenesis but is dispensable for centriolar satellite function. This ciliogenic function is mediated in part by the Rab8 GDP/GTP exchange factor, which localizes to the basal body and contacts the BBSome. Rab8(GTP) enters the primary cilium and promotes extension of the ciliary membrane. Firstly the BBSome associates with the ciliary membrane and binds to RAB3IP/Rabin8, the guanosyl exchange factor (GEF) for Rab8 and then the Rab8-GTP localizes to the cilium and promotes docking and fusion of carrier vesicles to the base of the ciliary membrane. The BBSome complex, together with the LTZL1, controls SMO ciliary trafficking and contributes to the sonic hedgehog (SHH) pathway regulation. Required for BBSome complex ciliary localization but not for the proper complex assembly.
仅用于科研。不用于诊断过程。未经明确授权不得转售。
篇参考文献 (0)
生物信息学
蛋白别名: Bardet-Biedl syndrome 5 protein; BBSome complex member BBS5
基因别名: BBS5
UniProt ID: (Human) Q8N3I7
Entrez Gene ID: (Human) 129880